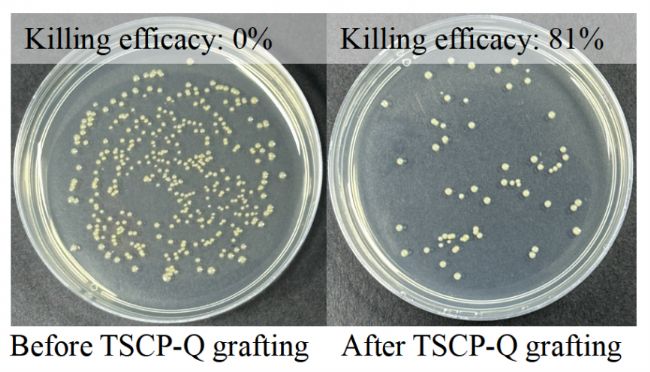

利用石英晶體微天平研究單鏈粒子的接枝動力學
復旦大學陳道勇課題組利用石英晶體微天平研究蝌蚪狀單鏈粒子的接枝動力學和應用
聚合物刷已經被廣泛應用于表面潤滑、生物防污和調控表面能等方面,但是往往存在制備復雜、接枝密度不高和長時間穩定性不足的難題。蝌蚪狀單鏈粒子(TSCP)是一種對兩嵌段共聚物進行鏈內交聯形成的Janus粒子,具有動態穩定性和環境響應性,因而在聚合物刷的制備方面受到了廣泛的關注。
蝌蚪狀單鏈粒子的鏈內交聯區域為“頭部”,而未交聯的線性高分子鏈為“尾巴”。通過對自由體積顯著收縮的“頭部”進行功能化,使“頭部”有幾十甚至上百個相互作用基團,可以獲得具有高密度活性基團的蝌蚪狀單鏈粒子。在接枝過程中,“頭部”與表面協同多種非共價弱相互作用,從而可在活性或惰性表面上制備穩定且均勻的聚合物刷,避免了傳統“Grafting From”的制備復雜性。此外,由于“頭部”塌縮后較小的尺寸,占據的表面積較小,這使得單位面積可以容納足夠多的蝌蚪狀單鏈粒子,從而實現高密度接枝。進一步,當“尾巴”的分子量足夠大時(~ 575 kg/mol),可以有效地覆蓋“頭部”與接枝表面,從而形成均勻且致密的覆蓋層,解決了傳統“Grafting To”的低密度接枝難題。另外,使用蝌蚪狀單鏈粒子作為接枝單元,可以正交控制“頭部”與表面的相互作用以及聚合物刷的特性。課題組利用耗散型石英晶體微天平對蝌蚪狀單鏈粒子的接枝動力學與穩定性進行了細致的表征。該工作以“Stably Grafting Polymer Brushes on Both Active and Inert Surfaces Using Tadpole-Like Single-Chain Particles with an Interactive “Head” ”為題,于2024年在線發表在ACS Macro Letters雜志上,第一作者為博士生趙曉雅,研究獲益于李達華博士的核心數據支撐。
通過聚苯乙烯-b-聚(4-乙烯基吡啶)(PS-b-P4VP)嵌段的P4VP鏈內交聯制備得到蝌蚪狀單鏈粒子(TSCP),可在硅片表面實現均勻接枝(圖1)。在接枝過程中,通過“頭部”與表面之間的多種相互作用的協同作用,“頭部”可以牢固地粘附在活性表面和惰性表面上;即使是接枝到惰性表面上,通過多種弱相互作用的集合和協同作用,TSCPs 仍能實現穩定的接枝(圖2)。

圖1 (A) TSCP的化學結構及接枝過程;(B) TSCP在不同倍率下的AFM高度圖

圖2 TSCP在活性表面和惰性表面的接枝示意圖
使用帶耗散的石英晶體微天平(QCM-D)對聚合物刷的吸附動力學進行了更細致的監測(圖3A),流速均為10 μL min-1。TSCP-1依次經歷了快速吸附和慢速構象重排,在構象重排過程中,∆D略有下降,表明松散吸附的TSCP-1層重組為緊密層。經DMF沖洗后,少量弱吸附的TSCP-1被去除,∆f略有增加。TSCP-1刷比季銨化的PS-b-P4VP(SV-Q-1)刷吸附更緊密,在相同的∆f下,ΔD更低(圖3B),說明吸附緊密的聚合刷能量損失更少,因此耗散略有變化。在依次用DMF、甲苯、氯仿、甲醇沖洗刷子并返回DMF后,Δf和ΔD最終恢復到第一次DMF沖洗時的初始值,這表明TSCP-1刷接枝具有極佳的穩定性(圖3C)。使用Kelvin-Voigt粘彈性模型計算得出,與SV-Q-1刷子(8.6 nm,857.3 ng/cm2)相比,緊密吸附的TSCP-1刷子的水合厚度更厚,水合質量更大(13.1 nm,1314.9 ng/cm2)(圖3D, E),表明TSCP-1和SV-Q-1刷具有截然不同的吸附姿態。

圖3 (A) TSCP-1和SV-Q-1的QCM-D吸附動力學,接枝濃度均為為0.2 mg/mL;(B) TSCP-1和SV-Q-1接枝過程中的ΔD vsΔf圖;(C) QCM-D監測TSCP-1聚合物刷的溶劑穩定性;TSCP-1和SV-Q-1在DMF中吸附的QCM-D厚度(D)和水合質量變化(E)。
上述研究表明,基于蝌蚪狀單鏈粒子的多位點非共價協同接枝能夠通過簡單的溶液浸泡方法制備高密度且均勻的聚合物刷。基于這一成果,課題組通過分子設計實現了高性能生物防污表面的設計,并以“具有抗蛋白黏附與抗菌性能的蝌蚪狀單鏈粒子刷的構筑”為題,于2024年在線發表于高分子學報,第一作者為直博生朱杰,受到了李達華博士的大力支持。材料表面受到細菌和硅藻等微生物附著和生長會迅速降低材料的生物相容性、力學性能和使用壽命,因此,“生物防污”在醫療植入器械和航海工業等領域具有重要意義。當前實現“生物防污”的主要策略之一是在材料表面接枝聚乙二醇(PEG)刷。然而,由于PEG刷難以原位聚合,現有的制備方法主要采用“Grafting To”策略,存在操作便捷性、穩定性和抗蛋白黏附性能的權衡。
采用“靜電介導”法制備了聚乙二醇-b-聚(4-乙烯基吡啶)蝌蚪狀單鏈粒子(TSCP-Q),并通過簡單的溶液浸泡獲得了均勻的PEG刷(圖4)。利用耗散型石英晶體微天平(QCM-D)跟蹤了TSCP-Q在氧化硅芯片表面的吸附動力學。基于TSCP-Q與氧化硅表面的多位點協同作用,其接枝過程體現出“快吸附-慢調整”的特性。進一步,利用QCM-D跟蹤牛血清蛋白(BSA)在TSCP-Q修飾表面的吸附動力學。相較于未修飾的表面,TSCP-Q刷修飾表面的BSA吸附量顯著減少,且吸附平衡時間明顯縮短。這是由于均勻PEG刷的體積排斥、快速構象轉變以及緊密水合層,可以有效抵抗BSA粘附(4.8 ng/cm2)(圖5, 6)。

圖4 (A) TSCP-Q的化學結構;(B) TSCP-Q接枝后的硅片表面具有良好的“生物防污”功能。

圖5 (A) TSCP-Q在在氧化硅芯片表面的吸附動力學曲線;(B) BSA在TSCP-Q刷表面的吸附動力學曲線;(C)TSCP-Q刷抗蛋白粘附的性能比較圖。

圖6 TSCP-Q刷的抗蛋白粘附示意圖。
利用(S. aureus)對TSCP-Q接枝的硅片表面進行抗菌評價。由于TSCP-Q的“尾部”PEG能夠動態穿透細胞膜,并促進細菌與TSCP-Q“頭部”的高密度季銨鹽接觸,所以TSCP-Q修飾的硅片對S. aureus體現出良好的抗菌性(81%)(圖7, 8)。

圖7 TSCP-Q刷的抗菌示意圖。

圖8 TSCP-Q刷的抗菌性能。
總結:基于對多位點非共價協同作用的理解和QCM-D表征,上述研究提出了一種通用的制備蝌蚪狀單鏈粒子刷的新方法。利用這一方法制備的聚合物刷具有高密度、均勻分布且分子量較大的特點,不僅成功地解決了傳統“Grafting To”低密度和“Grafting From”不均勻的學術難題,還為各類功能表面的構筑提供了高效的解決途徑。
導師簡介:

陳道勇 教授
陳道勇博士2000年加入復旦大學高分子科學系,2005年晉升教授。2008年獲國家自然科學基金杰出青年基金贊助,2011年入選“上海市優秀學科帶頭人”,并獲國家自然科學二等獎(第二獲獎人)。陳道勇目前擔任《Macromolecular Rapid Communications》、《化學通報》編委,已在Acc. Chem. Res.、Prog. Polym. Sci.、J. Am. Chem. Soc.、Angew. Chem. Int. Ed.、Macromolecules、ACS Macro Lett.等期刊上發表論文100余篇。
 黃霞蕓 副教授
黃霞蕓 副教授
黃霞蕓博士2016年加入復旦大學高分子科學系,任青年副研究員。2021年晉升為副教授,任聚合物分子工程國家重點實驗室固定研究人員。她在2014年獲得美國德州農工大學博士學位,研究功能性雜化聚電解質多層膜的制備。隨后,加入Experimental Soft Matter實驗室從事膠體液晶的博士后研究。她的研究方向是聚合物Janus納米粒子的高效制備及其功能化應用。主持國家自然科學基金面上基金和青年基金,獲上海市浦江人才項目以及Journal of Material Chemistry A新銳科學家稱號。以第一作者或通訊作者在ACS Macro Lett.、Chem. Commun.等期刊上發表論文30余篇。
原文鏈接:
Xiaoya Zhao, Dahua Li, Jie Zhu, Yanbin Fan, Jiayin Xu, Xiayun Huang, Zhihong Nie, Daoyong Chen. Stably Grafting Polymer Brushes on Both Active and Inert Surfaces Using Tadpole-Like Single-Chain Particles with an Interactive “Head”. ACS Macro Lett., DOI: 10.1021/acsmacrolett.4c00341
朱杰, 吳乃冰, 趙曉雅, 范艷斌, 黃霞蕓, 陳道勇. 具有抗蛋白黏附與抗菌性能的蝌蚪狀單鏈粒子刷的構筑. 高分子學報, 2024, 55, 900-909.
聚合物刷已經被廣泛應用于表面潤滑、生物防污和調控表面能等方面,但是往往存在制備復雜、接枝密度不高和長時間穩定性不足的難題。蝌蚪狀單鏈粒子(TSCP)是一種對兩嵌段共聚物進行鏈內交聯形成的Janus粒子,具有動態穩定性和環境響應性,因而在聚合物刷的制備方面受到了廣泛的關注。
蝌蚪狀單鏈粒子的鏈內交聯區域為“頭部”,而未交聯的線性高分子鏈為“尾巴”。通過對自由體積顯著收縮的“頭部”進行功能化,使“頭部”有幾十甚至上百個相互作用基團,可以獲得具有高密度活性基團的蝌蚪狀單鏈粒子。在接枝過程中,“頭部”與表面協同多種非共價弱相互作用,從而可在活性或惰性表面上制備穩定且均勻的聚合物刷,避免了傳統“Grafting From”的制備復雜性。此外,由于“頭部”塌縮后較小的尺寸,占據的表面積較小,這使得單位面積可以容納足夠多的蝌蚪狀單鏈粒子,從而實現高密度接枝。進一步,當“尾巴”的分子量足夠大時(~ 575 kg/mol),可以有效地覆蓋“頭部”與接枝表面,從而形成均勻且致密的覆蓋層,解決了傳統“Grafting To”的低密度接枝難題。另外,使用蝌蚪狀單鏈粒子作為接枝單元,可以正交控制“頭部”與表面的相互作用以及聚合物刷的特性。課題組利用耗散型石英晶體微天平對蝌蚪狀單鏈粒子的接枝動力學與穩定性進行了細致的表征。該工作以“Stably Grafting Polymer Brushes on Both Active and Inert Surfaces Using Tadpole-Like Single-Chain Particles with an Interactive “Head” ”為題,于2024年在線發表在ACS Macro Letters雜志上,第一作者為博士生趙曉雅,研究獲益于李達華博士的核心數據支撐。
通過聚苯乙烯-b-聚(4-乙烯基吡啶)(PS-b-P4VP)嵌段的P4VP鏈內交聯制備得到蝌蚪狀單鏈粒子(TSCP),可在硅片表面實現均勻接枝(圖1)。在接枝過程中,通過“頭部”與表面之間的多種相互作用的協同作用,“頭部”可以牢固地粘附在活性表面和惰性表面上;即使是接枝到惰性表面上,通過多種弱相互作用的集合和協同作用,TSCPs 仍能實現穩定的接枝(圖2)。

圖1 (A) TSCP的化學結構及接枝過程;(B) TSCP在不同倍率下的AFM高度圖

圖2 TSCP在活性表面和惰性表面的接枝示意圖
使用帶耗散的石英晶體微天平(QCM-D)對聚合物刷的吸附動力學進行了更細致的監測(圖3A),流速均為10 μL min-1。TSCP-1依次經歷了快速吸附和慢速構象重排,在構象重排過程中,∆D略有下降,表明松散吸附的TSCP-1層重組為緊密層。經DMF沖洗后,少量弱吸附的TSCP-1被去除,∆f略有增加。TSCP-1刷比季銨化的PS-b-P4VP(SV-Q-1)刷吸附更緊密,在相同的∆f下,ΔD更低(圖3B),說明吸附緊密的聚合刷能量損失更少,因此耗散略有變化。在依次用DMF、甲苯、氯仿、甲醇沖洗刷子并返回DMF后,Δf和ΔD最終恢復到第一次DMF沖洗時的初始值,這表明TSCP-1刷接枝具有極佳的穩定性(圖3C)。使用Kelvin-Voigt粘彈性模型計算得出,與SV-Q-1刷子(8.6 nm,857.3 ng/cm2)相比,緊密吸附的TSCP-1刷子的水合厚度更厚,水合質量更大(13.1 nm,1314.9 ng/cm2)(圖3D, E),表明TSCP-1和SV-Q-1刷具有截然不同的吸附姿態。

圖3 (A) TSCP-1和SV-Q-1的QCM-D吸附動力學,接枝濃度均為為0.2 mg/mL;(B) TSCP-1和SV-Q-1接枝過程中的ΔD vsΔf圖;(C) QCM-D監測TSCP-1聚合物刷的溶劑穩定性;TSCP-1和SV-Q-1在DMF中吸附的QCM-D厚度(D)和水合質量變化(E)。
上述研究表明,基于蝌蚪狀單鏈粒子的多位點非共價協同接枝能夠通過簡單的溶液浸泡方法制備高密度且均勻的聚合物刷。基于這一成果,課題組通過分子設計實現了高性能生物防污表面的設計,并以“具有抗蛋白黏附與抗菌性能的蝌蚪狀單鏈粒子刷的構筑”為題,于2024年在線發表于高分子學報,第一作者為直博生朱杰,受到了李達華博士的大力支持。材料表面受到細菌和硅藻等微生物附著和生長會迅速降低材料的生物相容性、力學性能和使用壽命,因此,“生物防污”在醫療植入器械和航海工業等領域具有重要意義。當前實現“生物防污”的主要策略之一是在材料表面接枝聚乙二醇(PEG)刷。然而,由于PEG刷難以原位聚合,現有的制備方法主要采用“Grafting To”策略,存在操作便捷性、穩定性和抗蛋白黏附性能的權衡。
采用“靜電介導”法制備了聚乙二醇-b-聚(4-乙烯基吡啶)蝌蚪狀單鏈粒子(TSCP-Q),并通過簡單的溶液浸泡獲得了均勻的PEG刷(圖4)。利用耗散型石英晶體微天平(QCM-D)跟蹤了TSCP-Q在氧化硅芯片表面的吸附動力學。基于TSCP-Q與氧化硅表面的多位點協同作用,其接枝過程體現出“快吸附-慢調整”的特性。進一步,利用QCM-D跟蹤牛血清蛋白(BSA)在TSCP-Q修飾表面的吸附動力學。相較于未修飾的表面,TSCP-Q刷修飾表面的BSA吸附量顯著減少,且吸附平衡時間明顯縮短。這是由于均勻PEG刷的體積排斥、快速構象轉變以及緊密水合層,可以有效抵抗BSA粘附(4.8 ng/cm2)(圖5, 6)。

圖4 (A) TSCP-Q的化學結構;(B) TSCP-Q接枝后的硅片表面具有良好的“生物防污”功能。

圖5 (A) TSCP-Q在在氧化硅芯片表面的吸附動力學曲線;(B) BSA在TSCP-Q刷表面的吸附動力學曲線;(C)TSCP-Q刷抗蛋白粘附的性能比較圖。

圖6 TSCP-Q刷的抗蛋白粘附示意圖。
利用(S. aureus)對TSCP-Q接枝的硅片表面進行抗菌評價。由于TSCP-Q的“尾部”PEG能夠動態穿透細胞膜,并促進細菌與TSCP-Q“頭部”的高密度季銨鹽接觸,所以TSCP-Q修飾的硅片對S. aureus體現出良好的抗菌性(81%)(圖7, 8)。

圖7 TSCP-Q刷的抗菌示意圖。
圖8 TSCP-Q刷的抗菌性能。
總結:基于對多位點非共價協同作用的理解和QCM-D表征,上述研究提出了一種通用的制備蝌蚪狀單鏈粒子刷的新方法。利用這一方法制備的聚合物刷具有高密度、均勻分布且分子量較大的特點,不僅成功地解決了傳統“Grafting To”低密度和“Grafting From”不均勻的學術難題,還為各類功能表面的構筑提供了高效的解決途徑。
導師簡介:

陳道勇 教授
陳道勇博士2000年加入復旦大學高分子科學系,2005年晉升教授。2008年獲國家自然科學基金杰出青年基金贊助,2011年入選“上海市優秀學科帶頭人”,并獲國家自然科學二等獎(第二獲獎人)。陳道勇目前擔任《Macromolecular Rapid Communications》、《化學通報》編委,已在Acc. Chem. Res.、Prog. Polym. Sci.、J. Am. Chem. Soc.、Angew. Chem. Int. Ed.、Macromolecules、ACS Macro Lett.等期刊上發表論文100余篇。

黃霞蕓博士2016年加入復旦大學高分子科學系,任青年副研究員。2021年晉升為副教授,任聚合物分子工程國家重點實驗室固定研究人員。她在2014年獲得美國德州農工大學博士學位,研究功能性雜化聚電解質多層膜的制備。隨后,加入Experimental Soft Matter實驗室從事膠體液晶的博士后研究。她的研究方向是聚合物Janus納米粒子的高效制備及其功能化應用。主持國家自然科學基金面上基金和青年基金,獲上海市浦江人才項目以及Journal of Material Chemistry A新銳科學家稱號。以第一作者或通訊作者在ACS Macro Lett.、Chem. Commun.等期刊上發表論文30余篇。
原文鏈接:
Xiaoya Zhao, Dahua Li, Jie Zhu, Yanbin Fan, Jiayin Xu, Xiayun Huang, Zhihong Nie, Daoyong Chen. Stably Grafting Polymer Brushes on Both Active and Inert Surfaces Using Tadpole-Like Single-Chain Particles with an Interactive “Head”. ACS Macro Lett., DOI: 10.1021/acsmacrolett.4c00341
朱杰, 吳乃冰, 趙曉雅, 范艷斌, 黃霞蕓, 陳道勇. 具有抗蛋白黏附與抗菌性能的蝌蚪狀單鏈粒子刷的構筑. 高分子學報, 2024, 55, 900-909.
Copyright(C) 1998-2025 生物器材網 電話:021-64166852;13621656896 E-mail:info@bio-equip.com






